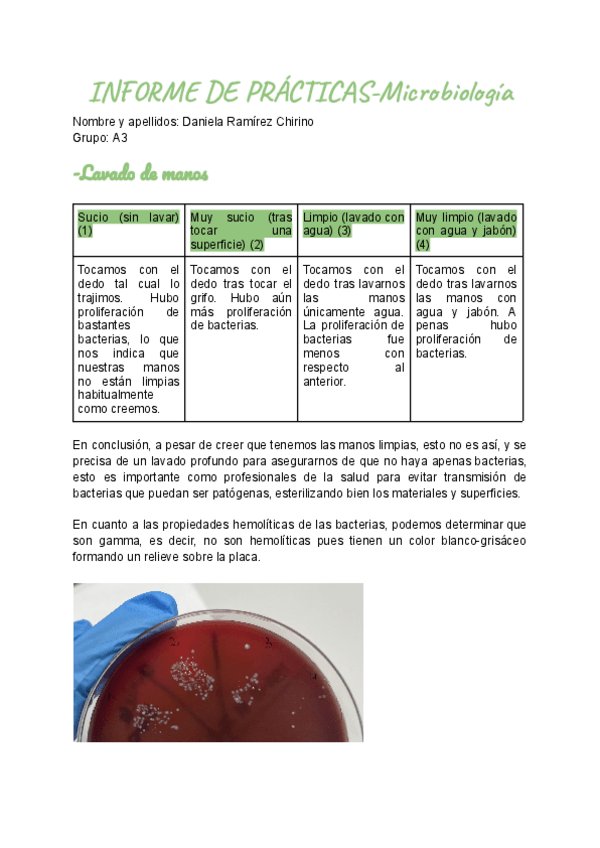

@danielaramirezc
Bio: Enfermería ULPGC
52 Publicaciones
431 Interacciones
3 Seguidores
6 Siguiendo
Lista de publicaciones de danielaramirezc
He publicado nuevos apuntes de 1º Fisiología: Cuaderno-de-Practicas-Fisiologia.docx
He publicado nuevos apuntes de 1º Farmacología: Practicas-Problemas.pdf
He publicado nuevos apuntes de 1º Farmacología: Problemas-para-practicar-1.pdf
He publicado nuevos apuntes de 1º Farmacología: Practicas-Problemas-ACTUALIZADO.pdf
apuntes
-
Preguntas examenes
He publicado nuevos apuntes de 1º Farmacología: Preguntas examenes
He publicado nuevos apuntes de 1º Estadística: Bloc-de-Estadistica.pdf
He publicado nuevos apuntes de 1º Nutrición y Dietética: PAula-1-Nutricion.docx
He publicado nuevos apuntes de 1º Nutrición y Dietética: PA05-Nutricion.pdf
He publicado nuevos apuntes de 1º Nutrición y Dietética: PA04-NUTRICION.pdf
He publicado nuevos apuntes de 1º Nutrición y Dietética: PA03-Nutricion.pdf
He publicado nuevos apuntes de 1º Nutrición y Dietética: PA02-Nutricion.pdf
He publicado nuevos apuntes de 1º Microbiología: Daniela-Informe-Practicas-Micro.pdf
He publicado nuevos apuntes de 1º Bioquímica: Informe-de-Practicas-BIOQUimica.docx
He publicado nuevos apuntes de 1º Inglés: segundo-parcial-ingles.docx
He publicado nuevos apuntes de 1º Biología: Practicas-4a-5a-y-6a-Biol-Enf-12-13.pdf